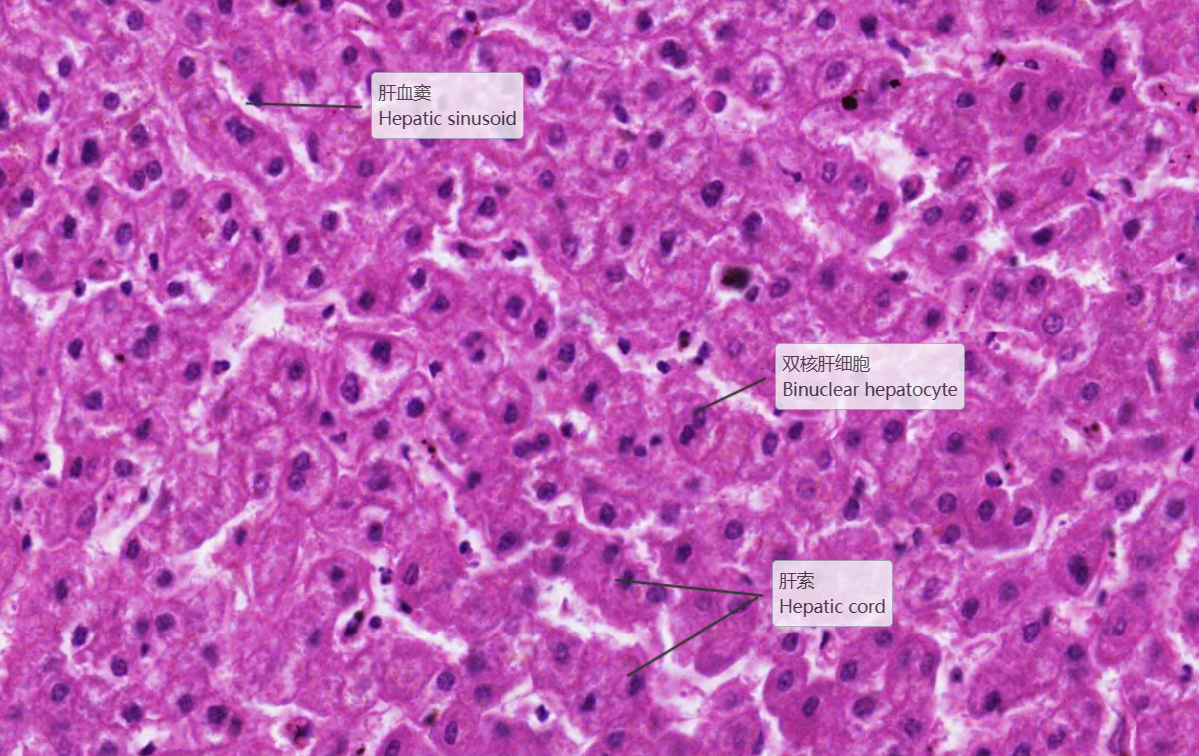

正常-病理对照图
-
1 肝
-
2 坏死后性肝硬化
上一节
下一节
低倍镜观察:1. 肝小叶:呈多边形或不规则形,界限不清。中央静脉位于肝小叶内,但并非完全位于中央,且有的肝小叶中找不到中央静脉(与肝小叶的切面有关)。肝板及肝血窦均比较清楚。2. 门管区:在邻近几个肝小叶之间的结缔组织内,三种伴行的管道:(1)小叶间动脉:腔小壁厚,可见中膜环行平滑肌。(2)小叶间静脉:腔大壁薄,有时可见与血窦相连续。(3)小叶间胆管:管径较小,管壁衬以单层立方上皮,细胞呈立方形,胞浆清明,细胞核呈圆形,着色较深。
1.全景图
 2.肝小叶
2.肝小叶


 3.中央静脉
3.中央静脉

4.肝血窦、肝细胞
5.门管区
5.门管区














